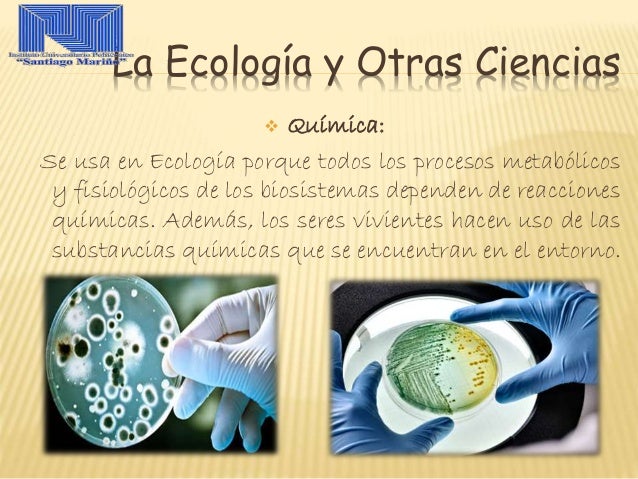

El administrador recopila información Relacion De La Quimica Con La Biologia Ejemplos.
Quimica Organica Clasificacion Caracteristicas Y Ejemplos

Fuente de : www.caracteristicas.co
Relacion De La Quimica Con La Biologia Que Relacion Tienen

Fuente de : www.visualavi.com
Las Corrientes En La Investigacion Bioquimica 1956 Veintisiete

Fuente de : www.alamy.es
Cual Es La Relacion De La Quimica Con La Medicina Lifeder

Fuente de : www.lifeder.com
Clasificacion De Las Ciencias

Fuente de : www.edu.xunta.gal
Relacion De La Biologia Con Otras Ciencias Lifeder

Fuente de : www.lifeder.com

Aquí está la información completa sobre relacion de la quimica con la biologia ejemplos. El administrador del blog Nuevo Ejemplo 10 January 2019 también recopila otras imágenes relacionadas con los relacion de la quimica con la biologia ejemplos a continuación.
Matematicas Y Quimica Una Relacion Necesaria Los Avances De La

Fuente de : educacionquimica.wordpress.com
Definicion De Biologia Molecular Que Es Significado Y Concepto

Fuente de : definicion.de
Ramas De La Biologia Y Sus Ciencias Auxiliares Cienciaybiologia Com

Fuente de : cienciaybiologia.com
Introduccion

Fuente de : www.bionova.org.es
La Quimica Y Los Alimentos Los Avances De La Quimica Educacion

Fuente de : educacionquimica.wordpress.com
Sabias Que Hay Relacion Entre La Biologia Y La Geologia

Fuente de : www.destinogea.es
Ejemplos De Biologia Universum El Mundo De La Ciencia

Fuente de : sites.google.com
La Fisica Y Su Relacion Con Otras Disciplinas O Ciencias

Fuente de : es.slideshare.net
Quimica Estefany2013

Fuente de : es.slideshare.net
Https Utperu Instructure Com Files 42433 Download Download Frd 1 Verifier Ivrwxjozgbf3brgavivgpf0l7k4jwue00waxfw4s

Fuente de :
Https Www Imus Us Es Act Rsme Rseq 2011 Php Herradon Pdf

Fuente de :
Que Ha Hecho La Quimica Por Nosotros Dciencia

Fuente de : www.dciencia.es
Relacion De La Ecologia Con Otras Ciencias
Fuente de : es.slideshare.net
Esa es la información que podemos describir acerca de relacion de la quimica con la biologia ejemplos. Gracias por visitar el sitio Nuevo Ejemplo 10 January 2019.